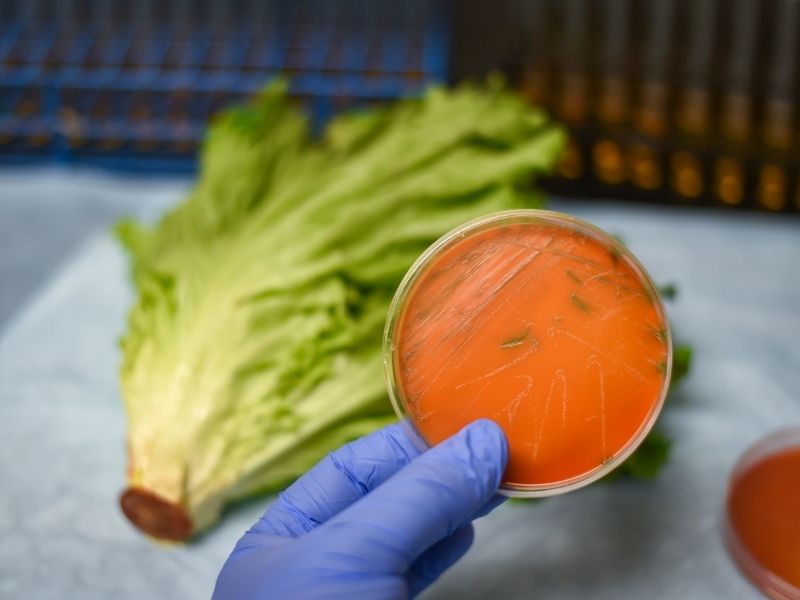
Nuevo Reglamento UE 2024/2895: Más control sobre Listeria en alimentos

Últimos Posts
- Acrilamida en alimentos: obligaciones para empresas
- Qué hacer ante una alerta alimentaria de AESAN: retirada de productos paso a paso
- Alerta AESAN: Gluten en harinas de trigo sarraceno etiquetadas “sin gluten”
- Denominación de hamburguesa en la UE: ¿adiós a las veggie burgers?
- ¿Cómo afecta la nueva Ley del desperdicio alimentario a bares y restaurantes?
